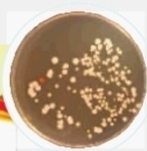

动态:绝味、久久丫被曝菌落指数严重超标,两年内三上黑榜
反思:缺乏标准化的湖南“鸭产业”如何突破发展瓶颈?

细菌超标让绝味鸭脖再陷质量风波。
近日,央视财经频道某节目曝光了北京几家大型超市和鸭脖店所出售的熟食中大肠杆菌数量超标的消息,其中绝味和久久丫均在列。绝味鸭脖的熟食鸭脖和鸭肠大肠杆菌数量比国家标准高出15倍和29.7倍,而这已经是绝味两年内第三次上黑榜。
9月11日,记者走访发现,长沙部分绝味鸭脖门店卫生堪忧,但销售员均表示生意未受影响。
长沙部分门店卫生堪忧
湖南人嗜辣,鲜香麻辣的卤鸭脖一直是湖南人的心头爱。此消息一出,众吃货都震惊了。然而记者走访长沙市场时发现,部分绝味鸭脖门店卫生状况的确堪忧。
在长沙火车站附近的一家绝味鸭脖店,记者看到,产品摆放的冷柜玻璃显得非常油腻,地板和柜台边角有陈年的污垢,一只苍蝇叮在玻璃板上。店员正在外间清理操作台,一瓶清洁剂随意摆放在冷柜上。十几分钟里,陆续有两三名客人进店购买熟食品。
在省中医院附近的一家绝味鸭脖店里,店主告诉记者,长沙地区的产品都是在长沙生产的,每天早上统一配送,保证都是新鲜干净的。“我们使用的砧板这一类的工具,都要求每两个小时消一次毒。”
而绝味公司方面的回应则称,对于加盟店的卫生都是有统一执行要求的,但是部分门店可能没有执行到位,这是导致产品菌落超标的重要原因。
七成网友拒吃绝味鸭脖
“绝味鸭脖卫生有问题,还是别买了”,这是记者在火车站附近绝味鸭脖店进行走访时听到的,绝味鸭脖菌落超标事件已经引起了消费者的强烈反响。
9月9日,腾讯网就“绝味鸭脖你还会买吗”的主题进行调查,532名湖南网友参加调查。其中超过70%的网友(420名)表示不会再买绝味鸭脖了。其中,认为不卫生不愿再买的共计305名,占到调查人数的近六成。认为不喜欢吃不会买的有69人,占比12.97%。有两成网友(115名)表示会继续购买,他们的理由是卤制品都这样。
虽然湖南绝味食品股份有限公司第一时间发表了声明,称对于央视报道的情况已展开调查,将及时公布调查结果,同时向消费者道歉,但大多数消费者显然并不买单。网友“小云”说:“细菌超标这么厉害,吃鸭脖变成吃细菌,太可怕了,以后尽量少吃,绝对不能再给孩子吃了。”
■三湘华声全媒体记者
肖祖华 实习生 唐娜
记者手记
湖南“鸭产业”亟需规范化发展
湖南的“鸭文化”由来已久,临武鸭、酱板鸭已经更为湖南美食的一张名片。但是,缺乏标准化和产业化的“湖南鸭”近年来遭遇发展的瓶颈。
在酱板鸭行业,无机砷超标的问题一直困扰着生产企业。此前,国家标准标准值是≤0.05mg/kg,然而在这一标准下,湖南的酱板鸭企业屡遭检测不合格,要保证这一标准的实现,就必须改变传统风味配方。经过权威专家反复论证后,酱板鸭无机砷含量新标准于今年6月1日起正式实施,标准值调为≤0.5mg/kg。日前,常德酱板鸭正式获得国家地理标志保护产品称号。
如今,散装熟食鸭产品也遭遇了酱板鸭曾经的困扰。绝味公司认为,用真空包装食品的标准来要求散装熟食达标,本身就是一个伪命题。
目前,我国在散装熟食方面还缺乏真正的标准,使得这一行业门槛低,管理混乱,严重制约行业的健康发展。“鸭产业”是湖南特色产业的重要支柱,想要发展好这一品牌,服务好消费者,标准的呵护必不可少。
来源:三湘都市报
作者:肖祖华 实习生 唐娜
编辑:白玲川